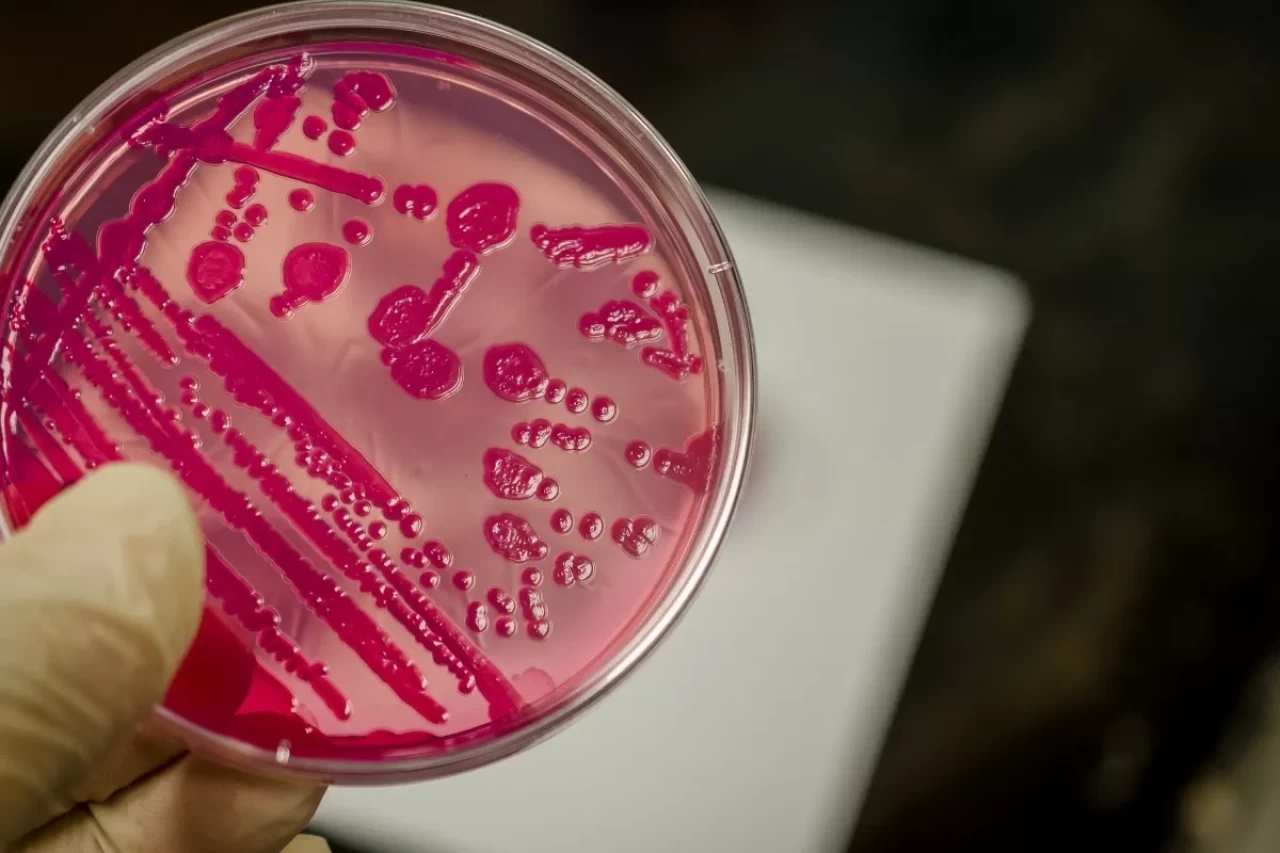

Mikrobiyolog Dr. Öğr. Üyesi İpek Ada Alver, yaz aylarının gelmesiyle birlikte gıda zehirlenmesi vakalarında artış yaşandığına dikkat çekerek, özellikle iyi pişirilmemiş tavuk, kırmızı et, yumurta, süt ürünleri ve mayonez gibi sosların ciddi risk taşıdığını belirtti. Bu tür gıdalardan kaynaklı zehirlenmelerin, genellikle oral yolla yani ağızdan bulaştığını söyleyen Alver, kontaminasyonun en sık personel ve mutfak hijyeni eksikliğinden kaynaklandığını vurguladı.

Hijyen Eksikliği, Gıda Güvenliğini Tehdit Ediyor
Dr. Alver, söz konusu Salmonella bakterisi‘nin; yetersiz pişirme, uygun olmayan depolama koşulları, el hijyenine dikkat edilmemesi ve sinek, böcek, fare gibi vektörler aracılığıyla yayılabildiğini belirtti. Bu etkenlerin bir araya gelmesiyle bakterinin hem doğrudan hem de çapraz bulaşma yolu ile yayılabileceğini ifade etti.
Salmonella Bağışıklığı Zayıflatıyor
Dr. Alver, bakterinin mide asidine dirençli olan türlerinin doğrudan ince bağırsağa yerleşerek burada hızla çoğaldığını belirtti. İnce bağırsağın geri emilim yapan bölümünde çoğalan bakteriler, virülans faktörleri ve toksinlerini salgılayarak bağışıklık sistemini zayıflatmakta, kana karışarak farklı organlara zarar vermektedir.
Bu Belirtiler Varsa Vakit Kaybetmeyin
Salmonelloz hastalığının belirtileri arasında halsizlik, mide bulantısı, kusma, ateş, karın ağrısı, ishal ve karında şişlik yer alıyor. Dr. Alver, özellikle kusma ve ishal ile birlikte gelişen sıvı kaybının ciddi sağlık sorunlarına neden olabileceğini belirterek, hastaların hızlıca hastaneye başvurması gerektiğini söyledi. Tedavi sürecinde sıvı-elektrolit desteği ve gerekirse antibiyotik tedavisi uygulanıyor.
Tavuk Ürünlerinde Gizlenen Tehlike
Dr. Alver, özellikle sıcak hava koşullarında bozulma riski artan tavuk ürünlerine dikkat çekerek, bazı işletmelerde bozuk ürünlerin sos ve baharatlarla kamufle edildiğini belirtti. Hijyen koşullarına uyulmadan hazırlanan ürünlerin ciddi sağlık tehditleri oluşturduğunu ifade eden Alver, “Birçok işletmede önceki günlerden kalma tavuk dönerin üzerine yeni ürün ekleniyor, bu da çapraz bulaşmaya zemin hazırlıyor” dedi.
Denetim Şart, Caydırıcı Cezalar Gerekli
Yüksek karbonhidrat, protein ve vitamin içeriğine sahip olan et, tavuk, süt ürünleri ve yumurta gibi gıdaların günlük beslenmede yer almasının önemli olduğuna değinen Dr. Alver, bu ürünlerden tamamen kaçınmak yerine denetimlerin sıklaştırılması gerektiğini vurguladı. Tavuk eti tüketimi konusunda toplumda oluşan endişelerin hem halk sağlığını hem de ekonomiyi tehdit ettiğini belirten Alver, “Hijyen kurallarına uymayan işletmelere caydırıcı cezalar uygulanmalı, çalışanlara hijyen eğitimi verilmelidir” dedi.